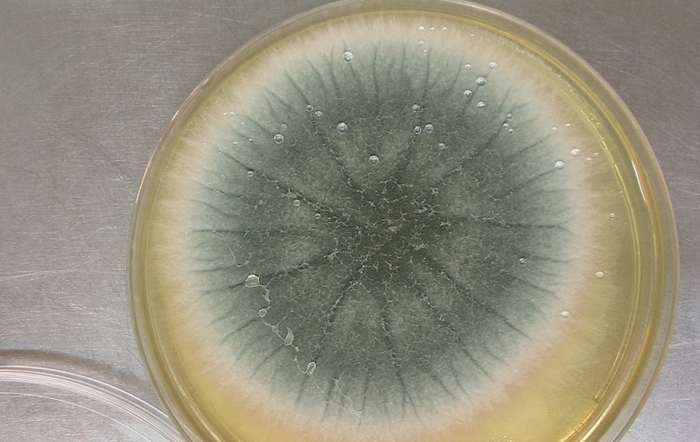

Consenso envolve 51 pesquisadores da área e cobra políticas públicas de prevenção contra o fungo causador da aspergilose, que já tem linhagens resistentes às drogas antifúngicas disponíveis. (Foto: Imagem: Wikipedia)
O fungo Aspergillus fumigatus, causador de uma doença chamada aspergilose invasiva, está evoluindo resistência aos poucos medicamentos capazes de detê-lo. Há apenas quatro classes de medicamentos antifúngicos no mercado, um número insuficiente diante da dimensão do problema — e a evolução de uma blindagem contra esse pequeno leque de terapias pode ter consequências graves para a saúde pública mundial nos próximos anos.
A preocupação com o tema motivou o Documento de Botucatu, uma moção pública de alerta aprovada em dezembro de 2025 durante um encontro entre 51 especialistas, 21 deles estrangeiros, na Faculdade de Ciências Agronômicas (FCA) da Unesp, em Botucatu (SP). Um dos líderes dessa iniciativa é o engenheiro agrônomo Paulo Ceresini, especialista em fitopatologia da Faculdade de Engenharia de Ilha Solteira (SP).
O texto reúne recomendações para enfrentar a resistência antifúngica no Brasil e no mundo a partir de um conceito conhecido como One Health (Saúde Única), que considera o bem-estar humano como inseparável da preservação ambiental e da qualidade de vida das demais espécies que compartilham a biosfera conosco.

O Brasil é um dos maiores consumidores mundiais de fungicidas agrícolas, especialmente da classe dos triazóis. Foto: Shutterstock
O artigo científico que embasa o Documento de Botucatu, explica que o Brasil é um dos maiores consumidores mundiais de fungicidas agrícolas, especialmente da classe dos triazóis. Esses compostos foram amplamente utilizados nas lavouras nas últimas três décadas e também constituem a base do tratamento médico contra infecções fúngicas graves.
A exposição constante deste fungo aos triazóis funciona como uma pressão seletiva darwiniana, que elimina os indivíduos suscetíveis ao fungicida. Apenas as linhagens que já nascem naturalmente resistentes a esses compostos, por causa de mutações fortuitas no genoma, são capazes de sobreviver e se reproduzir. Esse gargalo tem justamente o efeito de selecionar e ampliar a população dessas linhagens blindadas a medicamentos antes eficazes.
LEIA TAMBÉM:
→ O que o produtor precisa saber em relação à evolução da resistência de plantas daninhas nas lavouras
Outras características
Fora do ambiente agrícola, o Aspergillus fumigatus aparece em escala macroscópica como uma mancha verde-acinzentada de textura aveludada, que se adapta bem a ambientes secos de maneira incomum para os fungos — o que explica sua capacidade de se instalar em lugares inóspitos como dutos de ar-condicionado. Seus esporos, pequenos e ressequidos, são facilmente aerossolizados, o que o torna um contaminante comum em ambientes fechados de escritórios, por exemplo. Na natureza, porém, ele pode ser encontrado em habitats mais usuais, como matéria orgânica em decomposição.
Colônia de Aspergillus fumigatus observada com microsópio.Foto: Jankaan/Creative Commons
Em geral, o A. fumigatus é inofensivo. Todos nós inalamos alguns esporos diariamente e os eliminamos sem maiores problemas. Mas em pacientes imunossuprimidos ou com outras comorbidades — como recém-transplantados, pessoas com leucemia e pacientes de covid-19 — a aspergilose pode ser grave e, frequentemente, fatal. Calcula-se que a espécie cause 600 mil mortes todos os anos no mundo; número que tende a piorar se pessoas saudáveis começarem a sucumbir às variantes resistentes.
Segundo dados apresentados durante o encontro, a aspergilose ganhou força no Brasil nos últimos anos — foram cerca de 200 vítimas fatais em 2022 versus 800 em 2024 —, o que acompanha uma tendência observada internacionalmente. O uso de triazóis na agricultura brasileira também subiu de 20 mil toneladas anuais para 160 mil toneladas desde a introdução dessa classe de fungicidas no começo dos anos 2000. “A correlação não prova causalidade, obviamente, mas ela é um sinal de alerta importante”, resume Ceresini.
Monitoramento
O texto aprovado traz um consenso científico inédito em torno do tema. Ele recomenda que os dados sobre resistência antifúngica sejam coletados de forma auditável e divulgados com acesso aberto à sociedade, e que se crie um sistema nacional de monitoramento para acompanhar a presença de fungos resistentes no ar e no solo. “Não existe um sistema assim nem no Brasil nem fora, o documento é um marco”, diz o agrônomo.

O documento propõe que as agências reguladores exijam avaliações de risco mais rigorosas antes de aprovar produtos agrícolas capazes de estimular resistência a medicamentos humanos. Foto: Wolfgang Ehrecke/Pixabay
Além disso, o documento propõe que as agências reguladores exijam avaliações de risco mais rigorosas antes de aprovar produtos agrícolas capazes de estimular resistência a medicamentos humanos; que se amplie a capacidade dos hospitais de detectar infecções fúngicas e sua resistência e que se realize campanhas educativas voltadas a agricultores, profissionais de saúde, estudantes e ao público em geral.
Os Ministérios da Saúde, do Meio Ambiente e da Agricultura e Pecuária estão preparando a nova edição de seu Plano Nacional de Enfrentamento da Resistência Antimicrobiana (PANBR), que deverá orientar políticas públicas sobre o tema ao longo do próximo quinquênio. Os especialistas defendem que a resistência antifúngica, historicamente negligenciada, passe a ser abordada com clareza nesta próxima edição do documento.








